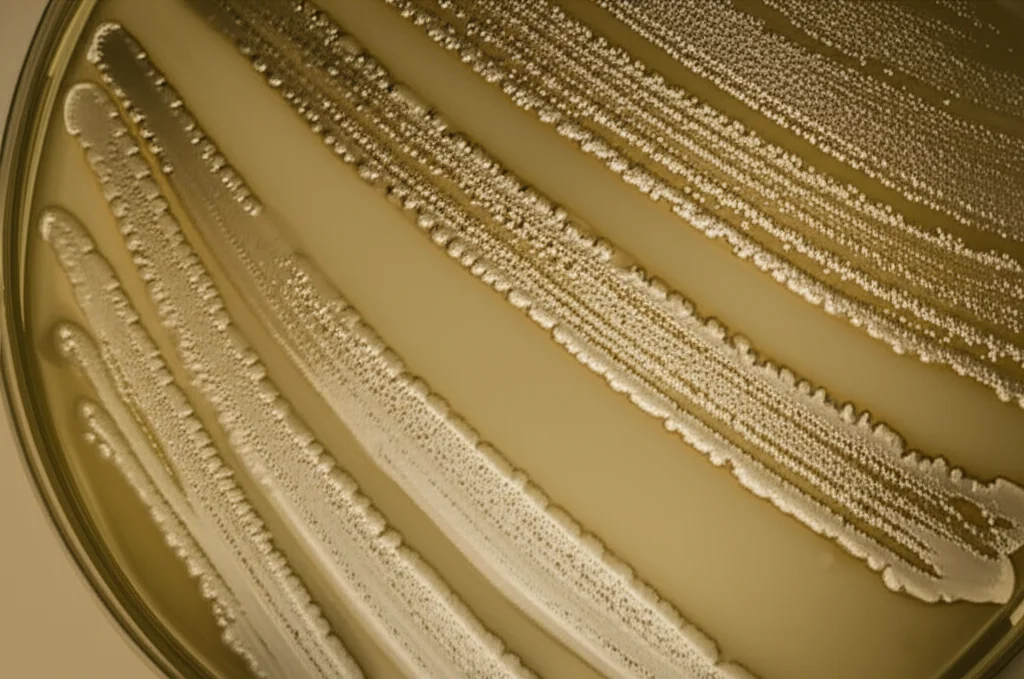
Immagine macro ad alta definizione di colonie batteriche diverse in una piastra di Petri, con illuminazione laterale drammatica per evidenziare le texture, simboleggiando la disbiosi del microbioma intestinale. Lente macro 60mm, messa a fuoco precisa, alta definizione.

Pappa di Notte in Gravidanza? Cervello Materno e Fetale a Rischio Infiammazione!
Ciao a tutti! Oggi voglio parlarvi di qualcosa che mi ha davvero colpito e che riguarda un momento speciale come la gravidanza. Sappiamo tutti quanto sia importante mangiare bene durante i nove mesi, ma avete mai pensato a *quando* mangiamo? Sembra un dettaglio, ma una nuova ricerca, per ora condotta sui ratti (che sono spesso i nostri “apripista” in laboratorio), suggerisce che invertire il normale ciclo giorno-notte per i pasti durante la gravidanza potrebbe avere effetti inaspettati sulla salute del cervello, sia della mamma che del piccolo in arrivo. E tutto passerebbe per il nostro affascinante secondo cervello: l’intestino!
L’esperimento: cosa abbiamo “combinato” in laboratorio
Immaginate dei ratti, animali notoriamente notturni, che quindi mangerebbero principalmente di notte. Bene, i ricercatori hanno preso un gruppo di future mamme ratto e le hanno “costrette” a mangiare solo durante il giorno, la loro fase di riposo, per tutta la durata della gravidanza. Un altro gruppo, invece, ha seguito la sua normale dieta notturna. La cosa importante è che entrambi i gruppi mangiavano la stessa quantità di cibo, quindi non era una questione di calorie in meno, ma proprio di *orario* sballato rispetto al loro orologio biologico. L’obiettivo? Capire se questo “mangiare controcorrente” potesse creare problemi.
Mamme stressate: ansia e infiammazione nel cervello
Ebbene sì, i risultati sono stati piuttosto chiari. Le mamme ratto costrette a mangiare di giorno hanno mostrato segni evidenti di comportamento simil-ansioso. Nei test comportamentali, erano più restie a esplorare spazi aperti, un classico indicatore di ansia nei roditori. Ma non è finita qui. Andando ad analizzare il loro sangue e il loro cervello, in particolare l’ippocampo (un’area cruciale per le emozioni e la memoria), abbiamo trovato livelli più alti di citochine infiammatorie (molecole come TNF-α, IL-6, IL-1β) e una ridotta capacità antiossidante. In pratica, il loro corpo e il loro cervello erano più “infiammati” e meno capaci di difendersi dallo stress ossidativo. E questa infiammazione sembrava correlata proprio ai comportamenti ansiosi osservati.
L’intestino sotto attacco: microbioma sballato e barriera colabrodo
Ma da dove arrivava tutta questa infiammazione? Gli indizi puntavano dritti all’intestino. Analizzando il contenuto intestinale delle mamme “fuori orario”, abbiamo scoperto un bel pasticcio nel loro microbioma intestinale. C’era una vera e propria disbiosi: batteri “buoni” come l’Akkermansia erano diminuiti, mentre altri potenzialmente problematici come la Dubosiella erano aumentati.
Ma non solo! La parete intestinale stessa sembrava aver perso la sua integrità. I geni responsabili delle “giunzioni strette” (quelle che tengono unite le cellule intestinali, formando una barriera) erano meno attivi. Risultato? Un intestino più permeabile, una sorta di “colabrodo” che lascia passare sostanze che non dovrebbero entrare nel flusso sanguigno. E infatti, anche nell’intestino abbiamo trovato livelli più alti di infiammazione.
L’orologio biologico impazzito (ma solo in periferia)
Un altro aspetto affascinante riguarda i ritmi circadiani, il nostro orologio biologico interno. Sappiamo che l’orario dei pasti è un segnale importante per sincronizzare gli orologi “periferici” presenti nei vari organi, come l’intestino. E infatti, nelle mamme che mangiavano di giorno, i geni che regolano l’orologio biologico nell’intestino erano completamente sballati, non seguivano più il loro normale ritmo di 24 ore. La cosa curiosa è che l’orologio centrale, quello nel cervello (nell’ipotalamo), sembrava invece funzionare normalmente. Era come se ci fosse una disconnessione tra il “capo” e gli “operai” periferici. E questa alterazione dei ritmi intestinali sembrava legata sia alla disbiosi che all’infiammazione locale.
Un “passeggero” indesiderato: l’LPS in viaggio
Qui arriva il punto cruciale. Con un microbioma alterato (più batteri Gram-negativi) e una barriera intestinale danneggiata, una particolare tossina batterica chiamata lipopolisaccaride (LPS) ha avuto vita facile. I livelli di LPS erano più alti nell’intestino delle mamme “fuori orario”, ma la cosa preoccupante è che abbiamo trovato livelli elevati di LPS anche nel loro sangue e persino nell’ippocampo! L’LPS è un potente attivatore dell’infiammazione (agisce su un recettore chiamato TLR4, anch’esso più espresso in queste mamme). Sembra proprio che questo LPS, partito dall’intestino scombussolato, sia riuscito a viaggiare nel corpo, raggiungendo il cervello materno e contribuendo all’infiammazione e all’ansia.

Effetti sul feto: un campanello d’allarme
E i piccoli? Purtroppo, gli effetti negativi non si sono fermati alla mamma. L’LPS materno in circolo è riuscito ad attraversare anche la barriera placentare, che a sua volta risultava danneggiata e più infiammata nelle mamme del gruppo “fuori orario”. Abbiamo infatti trovato livelli più alti di LPS e di marcatori infiammatori (come TNF-α, IL-6, IL-1β, TLR4) sia nella placenta che, cosa ancora più preoccupante, nel cervello dei feti. Anche la capacità antiossidante era ridotta nei piccoli. Inoltre, i feti di queste mamme pesavano meno alla nascita, e anche le placente erano più piccole, suggerendo uno sviluppo non ottimale. È interessante notare che alcuni di questi effetti sembravano essere un po’ più marcati nelle femmine rispetto ai maschi.
Cosa significa tutto questo?
Mettendo insieme i pezzi, questo studio sui ratti suggerisce un meccanismo preoccupante:
- Mangiare in orari “sbagliati” durante la gravidanza (contro il proprio ritmo naturale) può alterare profondamente il microbioma intestinale materno.
- Questa disbiosi, unita a un’alterazione dei ritmi circadiani intestinali, danneggia la barriera intestinale.
- Un intestino “colabrodo” permette alla tossina batterica LPS di passare nel sangue.
- L’LPS scatena infiammazione sistemica, raggiunge il cervello materno (contribuendo all’ansia) e danneggia la placenta.
- Attraverso la placenta compromessa, l’LPS arriva al cervello fetale, aumentando l’infiammazione anche lì.
- Tutto questo può compromettere lo sviluppo fetale (minor peso) e potenzialmente aumentare il rischio di problemi neuropsichiatrici futuri per il nascituro.

Certo, parliamo di ratti, e trasferire direttamente questi risultati agli esseri umani richiede cautela. La nostra fisiologia e i nostri cicli sono diversi. Tuttavia, pensiamo alle donne incinte che fanno turni di notte, o a chi osserva digiuni particolari come il Ramadan. Queste situazioni comportano spesso un’alterazione degli orari dei pasti. Questo studio è un campanello d’allarme: forse dovremmo prestare più attenzione non solo a *cosa* mangiamo in gravidanza, ma anche a *quando* lo facciamo. Mantenere una routine alimentare regolare e allineata il più possibile con il nostro orologio biologico potrebbe essere un piccolo gesto in più per proteggere la nostra salute e quella del bimbo che portiamo in grembo. È un campo di ricerca affascinante e ancora tutto da esplorare, ma che ci ricorda quanto siamo interconnessi: orari, intestino, cervello materno e sviluppo fetale… un equilibrio delicato da preservare!
Fonte: Springer
